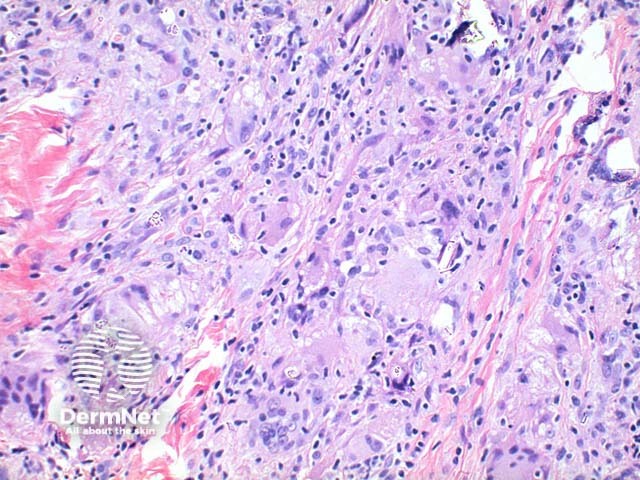
Figure 4

Main menu
Common skin conditions
NEWS
Join DermNet PRO
Read more
Quick links
Systemic diseases Diagnosis and testing
Author: Dr Ben Tallon, Dermatologist/Dermatopathologist, Tauranga, New Zealand, 2010.
Scanning power view of sarcoidosis shows a granulomatous reaction pattern (Figure 1) characterised by multiple discrete predominantly epithelioid granulomas (Figures 2 and 3). Necrosis is uncommonly seen. The granulomas are typically ‘naked’ with few surrounding lymphocytes and a rim of mild dermal fibrosis.
Asteroid bodies are star shaped cytoplasmic inclusions. Schaumann (conchoidal) bodies are concentrically lamellated calcified nodules seen within the cytoplasm of multinucleated cells. While frequently seen, these findings are not specific to sarcoidosis.
Foreign bodies are not uncommonly seen within sarcoidal granulomas (Figures 2, 3 and 4) and are more common within sites prone to trauma. The presence of birefringent material therefore does not exclude sarcoidosis. Foreign material may serve as a nidus for sarcoidal granuloma formation in some cases.

Figure 1

Figure 2

Figure 3
Figure 4
Infection: Granuloma-forming infections to be excluded comprise chiefly mycobacterial and fungal infections. These typically show more inflammation, caseous necrosis in tuberculosis and micro-organisms on special staining.
Foreign body reaction: A similar giant cell reaction to sarcoidosis may be present in foreign body reaction. Foreign material is evident on routine light and polaroscopic examination. Investigation for systemic sarcoidosis should be considered in selected cases.
Granulomatous rosacea: The infiltrate is lymphocyte dominant in the majority of cases of granulomatous rosacea, frequently with plasma cells. The granulomatous infiltrate is typically centered around pilosebaceous units.
Granulomatosis with polyangiitis: Displays basophilic necrosis containing neutrophils.